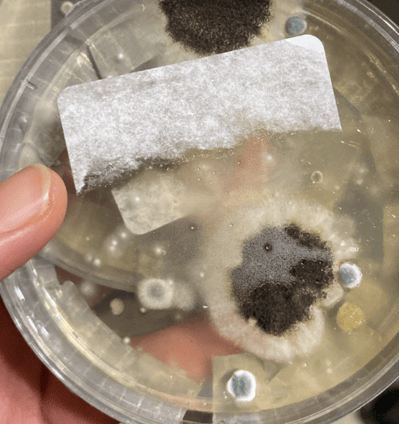
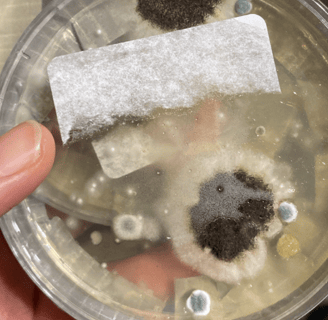

Recommended Products for Mold Prevention & Recovery
Explore Our Affiliate Recommended Products for Effective Mycotoxin & Parasite Management and Lymphatic Support.
Mold

Products to help against Mold.
Lymph
Write a short description of this category
Parasite
Write a short description of this category
Mold
Products to help with cleaning mold.
Jet Tub Covers
A variety of covers for jetted tubs to help
prevent mold growth.


coming soon
coming soon


Lymphatic Support
Products to support drainage pathways.
Boar Bristle Dry Brush
Supports lymphatic health.
Vegan Dry Brush
Supports lymphatic health.


coming soon
coming soon


Parasite Support
Products to support you while on a parasite cleanse.
10% Sulfur Soap
Sulfur Soap effectively reduces skin rashes and body odor with its antibacterial properties, promoting clearer and fresher skin. It's important to note that individuals with a sulfur allergy should avoid using this product. This soap is ideal for those seeking a gentle yet powerful solution for skin health and odor control.
coming soon
coming soon


coming soon
coming soon